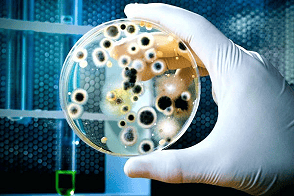

سم اکورد
سم آکورد چیست و چه کاربرد هایی دارد؟ هنگام خرید سم مخصوص محافظت از گیاهان، حتما شما هم با این سوال کلیدی مواجه شده اید. قارچ کش آکورد یک سم تماسی است که می تواند همه قارچ ها و آلودگی های موثر روی گیاه را تحت کنترل در آورد.قارچکش Accord با فرمولاسیون پودر وتابل 50 درصد (WP 50%) ساخت کشور سنگاپور میباشد امروز ما قصد داریم تا چیستی این سم و نکات مهم برای استفاده از آن را به صورت دقیق مورد بررسی قرار دهیم. پس با ما همراه شوید.
سم آکورد چیست؟
بیایید قبل از هر چیز چیستی قارچ کش آکورد را به صورت دقیق مورد بررسی قرار دهیم. آکورد، نوعی سم است که همراه با ماده موثر پروکلراز منگنز کلراید در اختیار مشتریان قرار می گیرد. این کالا یک قارچ کش تماسی بوده و در دنیای کشاورزی کاربرد های گسترده ای خواهد داشت. این وسیله را می توان برای کنترل آلودگی گیاهان و قارچ های ایجاد شده در آنها به کار برد. به خاطر داشته باشید که تست های انجام شده روی این کالا توانسته اند بازدهی آن را ثابت نمایند. همین مسئله هم باعث شده تا کاربران به خرید این سم علاقه زیادی داشته باشند.
بخوانید: خرید و قیمت قارچ دکمه ای عمده
مزایای استفاده از این سم
به نظر شما خرید سم آکورد چه مزایایی را به همراه دارد؟ اصلا چرا کاربران به استفاده از این سم علاقه مند هستند؟ داشتن کاربرد های گسترده در پروژه های مختلف توانسته روند به کار گیری این سم را متحول نماید. یک بار که این محصول را مورد استفاده قرار دهید، متوجه تاثیرات بلند مدت و فوق العاده آن خواهید شد. جدا از این مسئله، این سم قابلیت پیشگیری را نیز در خود جای داده است. با استفاده از این وسیله شما می توانید جلوی بروز بیماری ها و مشکلات مختلف را بگیرید. همین مسئله هم باعث شده تا کشاورزان در باغ ها و زمین های زراعی نسبت به استفاده از این وسیله اقدام نمایند.
کاربرد سم قارچ کش آکورد
سم قارچ کش آکورد یک سم تماسی از گروه ایمیدازول ها هست که دارای اثرات حفاظتی و درمانی در برابر آسکومیست ها و قارچ های ناقص است. از دیگر موارد مصرف سم آکورد کنترل و درمان بیماری قارچ های خوراکی و غلات ، برنج ، کلزا ، بقولات ، چغندرقند و گیاهان تزئینی است.
این سم در زمان استفاده به صورت محلول پاشی برای ضدعفونی بذرها و میوه مرکبات و نگهداری از درختان و میوه های گرمسیری پس از برداشت محصول استفاده میشود.
بخوانید: خرید سم دیازونین
عوارض سم قارچ کش آکورد
برای ایمن بودن از عوارض این قارچ کش در هنگام محلول پاشی باید از تجهیزات حفاظتی مانند دستکش و ماسک استفاده کنید و در صورت بروز هرگونه علائم مسمومیت مانند تهوع و استفراغ و گیجی و … به پزشک مراجعه کنید.
در صورت آلوده شدن لباس ها با این سم فورا آنها را تعویض کرده و محل را با آب فراوان شستشو دهید. برای پیشگیری از آلودگی های زیست محیطی وسایل سم پاشی را در آب های روان و رودخانه ها شستشو ندهید.
نکات مهم خرید سم آکورد
برای خرید سم آکورد شما باید چند نکته کلیدی را به خاطر بسپارید. برای شروع، بهتر است قیمت سم آکورد را مورد بررسی قرار دهید و مطمئن شوید که بر اساس نیاز خرید می کنید. قطعا آکورد یک سم ارزان قیمت نیست و برای تهیه آن شما باید بودجه مناسبی را در اختیار داشته باشید. جدا از این مسئله، شما باید به حجم خرید و استفاده از این کالا هم دقت نمایید. استفاده بیش از حد آکورد می تواند مشکلات زیادی را برای اکوسیستم گیاهان شما ایجاد کند.
بخوانید: قیمت و خرید کمپوست قارچ دکمه ای با کیفیت

بهترین راه خرید سم آکورد کدام است؟
علاقه مندان به خرید سم آکورد به صورت تک و عمده می توانند هم اکنون خدمات فروشگاه ما را مورد استفاده قرار دهند. انواع سم های عرضه شده در فروشگاه ما جدا از داشتن تعرفه معقولانه و پشتیبانی خوب، همراه با ضمانت روانه بازار می شوند. از همین رو، اگر شما هم قصد خرید یک سم با کیفیت، حرفه ای و خوش قیمت را دارید می توانید هم اکنون و با خیال راحت نسبت به استفاده از خدمات فروشگاه ما اقدام نمایید. کارشناسان ما آماده پاسخگویی به سوالات شما قبل از خرید هستند.
قارچ برتر با بیش از پانزده سال سابقه در تولید تجهیزات سالن قارچ با برند سهند هواساز و فروش مواد اولیه آماده خدمت رسانی به شماست .
برای کسب اطلاعات بیشتر و نحوه خرید تجهیزات سالن قارچ و مواد اولیه سالن قارچ تماس حاصل نمایید:
واحد فروش و امور مشتریان:
02156545904
09127021828






نقد و بررسیها
هنوز بررسیای ثبت نشده است.